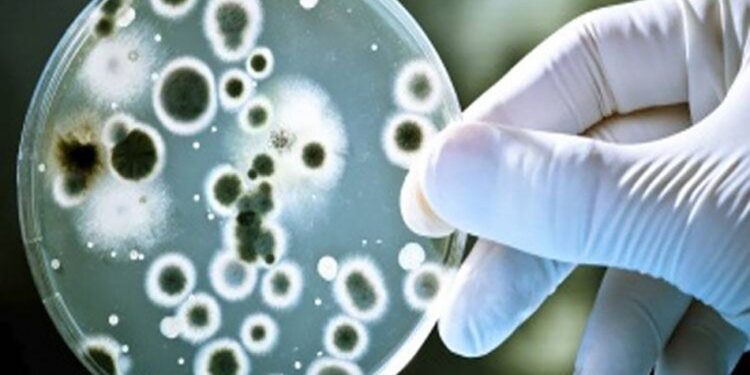
जळगाव जिल्ह्यात आढळला ‘लेप्टोस्पायरोसिस’ आजाराचा रुग्ण

केरळच्या कोझिकोडमध्ये दोन जणांचा मृत्यू झाल्यानंतर ही घटना निपाह व्हायरसमुळे झाल्याची भीती व्यक्त केली जात आहे. यानंतर संपूर्ण राज्यात अलर्ट जारी करण्यात आला आहे. निपाह विषाणू हा एक अनुवांशिक विषाणू आहे, जो प्राण्यांपासून मानवांमध्ये प्रवेश करतो आणि नंतर मानवांमध्ये पसरतो.सध्या या व्हायरसने केरळ मध्ये कहर केल्याने आरोग्य यंत्रणा अलर्ट झाली आहे.
काय आहेत निपाह व्हायरसची लक्षणे
निपाह व्हायरसची लक्षणे ताप, डोकेदुखी, खोकला, श्वास घेण्यास त्रास होणे आणि उलट्या होणे ही त्याची लक्षणे आहेत. अधिक गंभीर लक्षणांमध्ये गोंधळ, दौरे आणि अगदी कोमा यांचा समावेश होतो.
निपाह विषाणू हा एक अनुवांशिक विषाणू आहे, जो प्राण्यांपासून मानवांमध्ये प्रवेश करतो आणि नंतर मानवांमध्ये पसरतो. हा एक विषाणूजन्य संसर्ग आहे जो प्रामुख्याने वटवाघुळ, डुक्कर, कुत्रे आणि घोडे या प्राण्यांना प्रभावित करतो. या विषाणूचे नाव मलेशियातील एका गावाच्या नावावरून ठेवण्यात आले आहे, जिथे पहिल्यांदा याची नोंद झाली होती. फ्लाइंग फॉक्स नावाच्या वटवाघळामुळे त्याचा प्रसार होतो. विषाणूची लागण झालेल्या वटवाघळांमुळे हा संसर्ग मानवांमध्ये पसरतो.
इतकंच नाही तर कधी कधी चुकून खाल्लेली फळं खाल्ल्याने संसर्ग होण्याचा धोकाही निर्माण होतो. याची लागण झालेली व्यक्ती हा संसर्ग इतरांना पसरवते. डोकेदुखी, खोकला, श्वास घेण्यास त्रास होणे आणि उलट्या होणे ही लक्षणे आहेत. अधिक गंभीर लक्षणांमध्ये गोंधळ, दौरे आणि अगदी कोमा यांचा समावेश होतो. वर्ल्ड हेल्थ ऑर्गनायझेशन (WHO) नुसार, निपाह संसर्गाच्या प्रकरणांमध्ये मृत्यू दर 40 ते 75 टक्के आहे.
अद्याप उपचार नाही…
WHO च्या म्हणण्यानुसार, निपाहसाठी सध्या कोणतेही औषध किंवा लस उपलब्ध नाही. लोकांमध्ये निपाह संसर्ग कमी करण्याचा किंवा रोखण्याचा एकमेव मार्ग म्हणजे जनजागृती करणे. यामध्ये, खबरदारी म्हणून लोकांना खाण्याआधी फळे नीट धुवावीत आणि संक्रमित लोकांच्या संपर्कात आल्यानंतर खबरदारी घेण्यास सांगितले आहे. लोकांना मास्क घालण्याचाही सल्ला देण्यात आला आहे.
निपाह पासून वाचण्यासाठी हे करा…
निपाह व्हायरसपासून वाचण्यासाठी हात साबणाने धुवा डोळे किंवा तोंडाला वारंवार स्पर्श करणे टाळा वटवाघुळं राहत असलेल्या झाडांच्या किंवा इतर ठिकाणांच्या संपर्कात येणं टाळा. निरोगी खाण्याच्या सवयी ठेवा आणि पुरेसे पाणी प्या